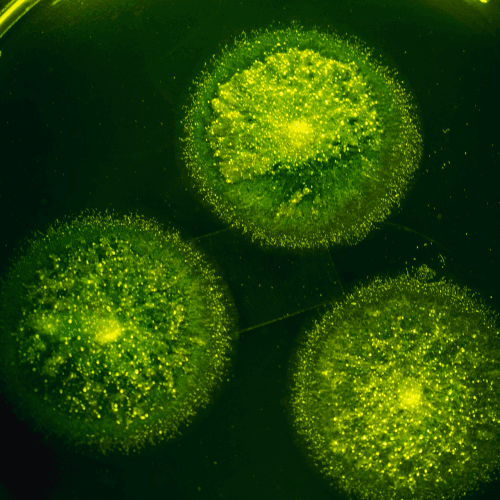
Biotoxin cellular visualization

How We’ve Helped Thousands of Patients Get Their Lives Back From Autoimmune Disease Without Tons of Supplements or a Strict Diet.
Even If They Were Told They Had To “Just Live With It” or There’s Nothing They Can Do…
What Our Patients Are Saying
Real results from patients across Nevada and beyond.
“After years of being told my Hashimoto's was 'managed' with medication, Dr. DeMartino actually found the root cause. Within weeks of starting his protocol, my energy came back and my brain fog lifted. I feel like a completely”
Sarah M., Henderson, NV
Verified Google review
“I was diagnosed with rheumatoid arthritis and told I'd be on immunosuppressants for life. Dr. DeMartino's approach using Quantum Neurology was unlike anything I'd experienced. My inflammation markers have dropped significantly and I'm moving without pain again.”
Michael R., Las Vegas, NV
Verified Google review
“I'd seen six different specialists for my fibromyalgia and chronic fatigue. Nobody could help. Dr. DeMartino was the first practitioner to actually explain what was happening in my body and give me a clear plan. I'm finally getting”
Jennifer K., Boulder City, NV
Verified Google review
“Dr. DeMartino's Frequency Specific Microcurrent treatments have been life-changing for my MS symptoms. I was skeptical at first, but the results speak for themselves. My neurologist is amazed at my progress.”
David L., Henderson, NV
Verified Google review
“After my lupus diagnosis, I felt hopeless. Every doctor just wanted to add another medication. Dr. DeMartino took the time to understand my whole health picture and created a protocol specific to me. I haven't felt this good”
Patricia W., Summerlin, NV
Verified Google review
“After years of being told my Hashimoto's was 'managed' with medication, Dr. DeMartino actually found the root cause. Within weeks of starting his protocol, my energy came back and my brain fog lifted. I feel like a completely”
Sarah M., Henderson, NV
Verified Google review
“I was diagnosed with rheumatoid arthritis and told I'd be on immunosuppressants for life. Dr. DeMartino's approach using Quantum Neurology was unlike anything I'd experienced. My inflammation markers have dropped significantly and I'm moving without pain again.”
Michael R., Las Vegas, NV
Verified Google review
“I'd seen six different specialists for my fibromyalgia and chronic fatigue. Nobody could help. Dr. DeMartino was the first practitioner to actually explain what was happening in my body and give me a clear plan. I'm finally getting”
Jennifer K., Boulder City, NV
Verified Google review
“Dr. DeMartino's Frequency Specific Microcurrent treatments have been life-changing for my MS symptoms. I was skeptical at first, but the results speak for themselves. My neurologist is amazed at my progress.”
David L., Henderson, NV
Verified Google review
“After my lupus diagnosis, I felt hopeless. Every doctor just wanted to add another medication. Dr. DeMartino took the time to understand my whole health picture and created a protocol specific to me. I haven't felt this good”
Patricia W., Summerlin, NV
Verified Google review
“After years of being told my Hashimoto's was 'managed' with medication, Dr. DeMartino actually found the root cause. Within weeks of starting his protocol, my energy came back and my brain fog lifted. I feel like a completely”
Sarah M., Henderson, NV
Verified Google review
“I was diagnosed with rheumatoid arthritis and told I'd be on immunosuppressants for life. Dr. DeMartino's approach using Quantum Neurology was unlike anything I'd experienced. My inflammation markers have dropped significantly and I'm moving without pain again.”
Michael R., Las Vegas, NV
Verified Google review
“I'd seen six different specialists for my fibromyalgia and chronic fatigue. Nobody could help. Dr. DeMartino was the first practitioner to actually explain what was happening in my body and give me a clear plan. I'm finally getting”
Jennifer K., Boulder City, NV
Verified Google review
“Dr. DeMartino's Frequency Specific Microcurrent treatments have been life-changing for my MS symptoms. I was skeptical at first, but the results speak for themselves. My neurologist is amazed at my progress.”
David L., Henderson, NV
Verified Google review
“After my lupus diagnosis, I felt hopeless. Every doctor just wanted to add another medication. Dr. DeMartino took the time to understand my whole health picture and created a protocol specific to me. I haven't felt this good”
Patricia W., Summerlin, NV
Verified Google review
“I drove from California to see Dr. DeMartino after hearing about his work with autoimmune conditions. Best decision I ever made. His knowledge of bioelectronic technology and functional medicine is unmatched.”
Robert T., Las Vegas, NV
Verified Google review
“The team at Superior Health Solutions genuinely cares. Dr. DeMartino spent over an hour with me on my first visit explaining the science behind his approach. No other doctor has ever given me that kind of attention or”
Karen S., Green Valley, NV
Verified Google review
“I was told to 'just live with' my chronic pain and autoimmune symptoms. Dr. DeMartino refused to accept that answer for me. His protocol addressed things no other practitioner had even tested for. I'm grateful beyond words.”
James H., Henderson, NV
Verified Google review
“Three years of going from specialist to specialist with no answers. One visit with Dr. DeMartino and I finally understood what was actually causing my symptoms. His approach is scientific, thorough, and compassionate.”
Linda C., Las Vegas, NV
Verified Google review
“Dr. DeMartino is the real deal. He doesn't just mask symptoms - he finds what's actually broken and fixes it. My autoimmune markers are better than they've been in a decade. I recommend him to everyone I know.”
Thomas B., Pahrump, NV
Verified Google review
“I drove from California to see Dr. DeMartino after hearing about his work with autoimmune conditions. Best decision I ever made. His knowledge of bioelectronic technology and functional medicine is unmatched.”
Robert T., Las Vegas, NV
Verified Google review
“The team at Superior Health Solutions genuinely cares. Dr. DeMartino spent over an hour with me on my first visit explaining the science behind his approach. No other doctor has ever given me that kind of attention or”
Karen S., Green Valley, NV
Verified Google review
“I was told to 'just live with' my chronic pain and autoimmune symptoms. Dr. DeMartino refused to accept that answer for me. His protocol addressed things no other practitioner had even tested for. I'm grateful beyond words.”
James H., Henderson, NV
Verified Google review
“Three years of going from specialist to specialist with no answers. One visit with Dr. DeMartino and I finally understood what was actually causing my symptoms. His approach is scientific, thorough, and compassionate.”
Linda C., Las Vegas, NV
Verified Google review
“Dr. DeMartino is the real deal. He doesn't just mask symptoms - he finds what's actually broken and fixes it. My autoimmune markers are better than they've been in a decade. I recommend him to everyone I know.”
Thomas B., Pahrump, NV
Verified Google review
“I drove from California to see Dr. DeMartino after hearing about his work with autoimmune conditions. Best decision I ever made. His knowledge of bioelectronic technology and functional medicine is unmatched.”
Robert T., Las Vegas, NV
Verified Google review
“The team at Superior Health Solutions genuinely cares. Dr. DeMartino spent over an hour with me on my first visit explaining the science behind his approach. No other doctor has ever given me that kind of attention or”
Karen S., Green Valley, NV
Verified Google review
“I was told to 'just live with' my chronic pain and autoimmune symptoms. Dr. DeMartino refused to accept that answer for me. His protocol addressed things no other practitioner had even tested for. I'm grateful beyond words.”
James H., Henderson, NV
Verified Google review
“Three years of going from specialist to specialist with no answers. One visit with Dr. DeMartino and I finally understood what was actually causing my symptoms. His approach is scientific, thorough, and compassionate.”
Linda C., Las Vegas, NV
Verified Google review
“Dr. DeMartino is the real deal. He doesn't just mask symptoms - he finds what's actually broken and fixes it. My autoimmune markers are better than they've been in a decade. I recommend him to everyone I know.”
Thomas B., Pahrump, NV
Verified Google review
Does This Sound Familiar?
You’re not imagining it. These problems have a root cause — and a solution that goes far beyond symptom management.
You've been diagnosed with an autoimmune disease - Hashimoto's, MS, lupus, rheumatoid arthritis, or another - and you've been told there's nothing they can do, only management.
You feel terrible, but your doctor says your labs look fine. Or your labs look awful, but nobody can explain why you still feel okay.
You've tried dozens of supplements, strict diets, and alternative therapies - but nothing has produced lasting results.
You've been dismissed, rushed, or told 'there's nothing I can do' by doctors who didn't have the tools or interest to dig deeper.
You want to understand the root cause of your condition - not just suppress symptoms with medications that weaken your immune system over time.
You refuse to accept that this is a lifelong sentence.
You're willing to invest time, effort, and resources to get your life back - but you need a clear path forward, not another cookie-cutter protocol.
You want reversal - not remission. You want this to go away completely.
If any of this resonates, you're exactly who Dr. DeMartino built this practice for.
The Root Cause Is Energetic Debt
All 188+ autoimmune diseases share the same one root cause.
Every condition on this list, no matter the diagnosis, traces back to the same underlying problem. We call it Energetic Debt.
What is Energetic Debt?
Energetic Debt is the body's inability to generate enough cellular energy to maintain immune balance, neurological function, and tissue repair. It comes down to three things:
- •Too much energy going out - chronic stress, infection, inflammation, or toxins drain the system faster than it can recover
- •Too little energy coming in - poor mitochondrial function, nutrient deficiencies, or disrupted sleep limit what the body can produce
- •Energy being mismanaged - the body cannot efficiently allocate what it has, leaving critical systems depleted and unable to heal
Health Challenges We Address at Superior Health Solutions
- ADD/ADHD
- ALS
- Adrenal Fatigue
- Aging
- Allergies
- Alzheimer's Disease
- Anxiety
- Arrhythmia
- Arthritis
- Autism
- Endocrine Disorders
- Biofilm
- Brain Fog
- Chronic Pain Syndromes
- Constipation
- Crohn's Disease
- Cystic Fibrosis
- Depression
- Diabetes
- Digestive Disorders
- EMF Sensitivity
- Ehlers-Danlos Syndrome
- Gerd (Acid Reflux)
- Gut Toxicity
- Hashimoto's
- Headaches
- Histamine Intolerance (HIT)
- Hormonal Imbalance
- Hypothyroidism
- Insomnia
- Irritable Bowel Syndrome
- Lupus
- Mast Cell Activation Syndrome (MCAS)
- Epilepsy
- Migraines
- Mold Toxicity
- POTS
- Panic Disorders
- PANS/PANDA
- Paralysis
- Parkinson's
- Tachycardia
- Tremors
- Vertigo
If your condition is on this list, or isn't, Energetic Debt is likely why you haven't gotten the results you deserve.
Why Was Superior Health Solutions Created?

Dr. Rob
DeMartino DC
Dr. Rob DeMartino, DC
What I'm about to share changed the course of my life. My parents tried for seven years to get pregnant with me. They already had my sister, but even with fertility treatments nothing worked. They finally got pregnant only after they stopped trying. Ask my Mom and she'll still call me her “miracle baby.”
Six months after I was born, my older sister developed pain around her left knee. The diagnoses ranged from growing pains, to wanting attention, to juvenile rheumatoid arthritis, until finally they discovered it was an aggressive bone cancer called Ewing's Sarcoma. From that moment, I knew I wanted to be a doctor. My parents did everything they could, and she fought for almost ten years, before passing away five weeks short of her 17th birthday.
I was devastated. Three months later, I started getting the most incredible migraines. I'd see spots in my eyes like someone flashed a camera, and from that point I had 45 minutes to get somewhere safe before it hit full force. No medication, nothing could stop it once it started.
“I would have to go in a dark and quiet room, cover my head in the blankets while trying not to move until I finally would throw up from the pain.”
I'd pass out and sleep for 10 hours to recover. This happened multiple times a week for FOUR years. I missed school, friends, fun. I was missing life. My parents took me to so many doctors looking for help.
Then my life changed when I went to a chiropractor. I didn't even go for my headaches. I'd hurt my lower back playing basketball. But he did a full exam and found my neck was so twisted it was putting pressure on my spinal cord, causing the migraines. Honestly, I didn't believe he could help. But I was willing to try anything.
Within two weeks my headaches were gone. Gone for good. After four years of doctor after doctor with zero results, I became obsessed with natural healing. That chiropractor took me to my first seminar when I was 14, and I knew that was what I wanted to do with my life.
I went through school and eventually entered chiropractic college. About two months in, my parents came to visit and sat me down for a serious talk. My Mom had been diagnosed with leukemia. This type typically had an 8-year life expectancy, and her numbers weren't good. Right then I knew I had to learn as many healing modalities as I could to support her. We'd been through this before as a family, but I was determined to make the outcome different.
After graduating and starting my own practice, I got involved in my Mom's care. We used many different healing approaches and technologies, and slowly her health improved. We began offering those treatments in our office and found they helped with many different conditions. I'm happy to report it's been 19 years since her diagnosis, and she is doing great.
Through all of this, I found my calling and purpose.
To make sure that people suffering with chronic disease, even if they were told there were no options, know that there are things they can do to improve and reclaim their health.
To your health,
Dr. Rob DeMartino, DC
Doctor of Chiropractic · Palmer College of Chiropractic, Magna Cum Laude · Founder, Superior Health Solutions
Wouldn't you want a practitioner focused on autoimmune recovery?
Dr. Rob DeMartino and the Superior Health Solutions team have become a destination practice for patients seeking root-cause resolution for autoimmune and chronic conditions - backed by real results.
Patients trust us from across the country
Superior Health Solutions has become a destination for patients who want answers - not just prescriptions. From across Nevada and around the country, patients choose Dr. DeMartino for his expertise in Quantum Neurology, Frequency Specific Microcurrent, and root-cause autoimmune recovery.
Our Methodology
Our Simple 3-Step Process. We harmonize these levers to get results with our patients, in the shortest time possible.
Accurate Data
Right Testing, Right Time, Right Data. To make accurate decisions without tons of testing.
Bioelectronics
Technology designed for healthcare, to enhance outcomes and supercharge healing.
Simplified Lifestyle
Focusing on the simple shifts that bring the most results without overhauling your lifestyle.
Why Frequency Works When Conventional Medicine Doesn't
Most doctors can't get results for autoimmune patients because they're working with the wrong model of the body.
Why conventional medicine falls short
They're solving the wrong science
Conventional medicine treats autoimmune as a chemistry problem - giving immune suppressors, anti-inflammatories, and supplements. But chemistry is not the governing science. Physics is. The body runs on energy, and no chemical can fix a physics problem.
The immune system is treated as the enemy
Suppressing the immune system removes the reaction - so patients feel slightly better - but it never solves the root cause. Worse, it accelerates cell deterioration, which is what triggered the immune response in the first place.
Blood work alone gives you an incomplete picture
Standard labs measure chemistry. They cannot tell you about the body's energetic state. This is why patients can have perfect labs and feel terrible - or terrible labs and feel surprisingly fine.
No methodological solution exists within the model
Traditional medicine, drugs, and surgery do not have a methodology for reversing autoimmune disease. The formula is: get a diagnosis, receive the standard medication for that label. Every patient. Every time.
The Body Is an Electrical System
The body is not just a collection of chemicals floating around - it is also an electrical system. Every cell maintains electrical charge and uses electrical signals to communicate and coordinate functions like healing, immune activity, and energy production. Frequency-based technologies interact with those signaling systems. Instead of adding chemicals like drugs or supplements, frequencies help stimulate and support the communication pathways the body already uses to regulate repair.
The technologies we use influence cellular signaling and mitochondrial function by interacting with the body's bioelectric systems. In fact, this concept of bioelectric signaling is why therapies like pacemakers, nerve stimulators, and brain stimulation already exist in conventional medicine. We are simply applying similar principles more broadly to help the body's regulatory systems communicate and function more effectively.
Real Patient Stories
Watch what patients are saying about their results with Dr. DeMartino
Real Reviews From Patients Like You
These are direct screenshots from patient feedback shared with our office and posted publicly online. Open any card to read it at full size.
Book Your Autoimmune Discovery Call
Your discovery call includes:
- Thorough review of your health history and current symptoms
- Clear explanation of our Quantum Neurology approach and how it applies to your condition
- Assessment of whether you're a fit for our protocol
- An honest evaluation - no pressure, no upselling

This Is For You If...
Frequently Asked Questions
Get answers to common questions about our approach to autoimmune recovery.
What conditions do you work with?
What is Quantum Neurology?
What is Frequency Specific Microcurrent?
How is this different from functional medicine?
Do you accept insurance?
How do I know if I'm a good fit?
Take the First Step Toward Recovery
Book your autoimmune discovery call with Dr. DeMartino.
“The body has an innate ability to heal - it just needs the right conditions.”
This Is Where Your Recovery Begins
Stop accepting that autoimmune disease is a life sentence. If you are ready to find the root cause of your condition and explore a path to recovery - this is where that conversation starts.